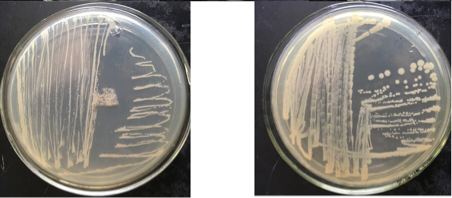

录入时间:2020-07-09 发布者:admin 访问次数:1832
通讯员 周蜜(文) 天芹(图)
根据长江师范学院应用型大学建设要求及《生物工程人才培养方案》计划,自2020年6月8日至2020年7月6日,2017级生物工程专业学生进行微生物基本技能竞赛。目的是通过竞赛培养学生的实际动手和操作能力,融会贯通课堂所学内容,增强学生的工程实践能力并为今后在工作中解决工程实际问题打下良好基础。由教务处主办,现代农业与生物工程学院承办的“微生物基本技能竞赛”在格律楼3304、3308、3309和3312微生物实验室举行。由生物工程系主任陈今朝教授主持,吴鹏飞,尚淑梅和杜萍老师担任评委。
本次比赛共有六支队伍参加,每组3-4人,分别参加点接种、划线分离和微生物血细胞计数三个项目的初赛和复赛。同学们积极参与,现场气氛既活跃又严肃。最终,经过近1个月的激烈竞赛,各组得到了各自微生物培养结果。并根据样品采集、无菌操作、接种、培养、结果呈现等几个方面进行评分,最终,评出一等奖、二等奖、三等奖和优秀奖,具体获奖结果如下。
二等奖:付小荣、许丹
三等奖:盘诗园、涂慧、周蜜、龚明珠
优秀奖:李桂湘、李飞、陈勇、李亚辉、何泽锋、马圆、阮玉婷、彭贵华、李玲、罗贝